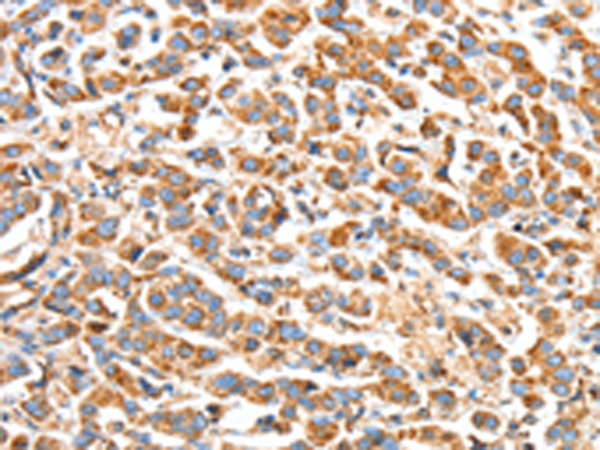
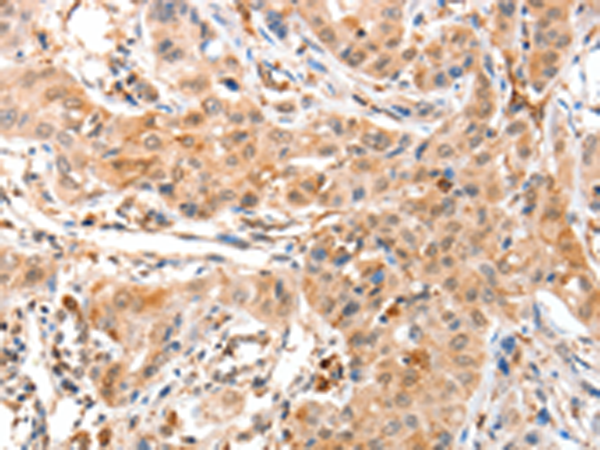
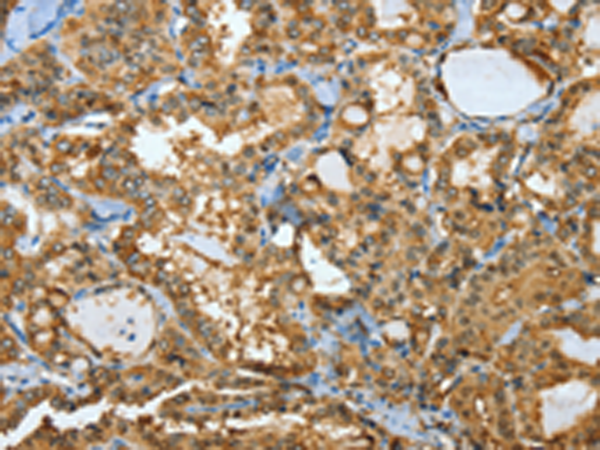

-
分类: 科研抗体货号: P00110别名: BAK; CDN1; BCL2L7; BAK-LIKE应用: WB,IHC反应种属: Human
-
分类: 科研抗体货号: P00106别名: IKBR; NFKBIL2应用: IHC反应种属: Human
-
分类: 科研抗体货号: P00167别名: K2e, KRTE, CK-2e, KRT2A, KRT2E应用: WB,IHC反应种属: Human, Mouse
-
分类: 科研抗体货号: P00103别名: IKBB; TRIP9应用: WB,IHC反应种属: Human, Rat
-
分类: 科研抗体货号: P00204别名: API4; EPR-1应用: IHC反应种属: Human, Mouse, Rat
-
分类: 科研抗体货号: P00158别名: ANX8应用: IHC反应种属: Human, Mouse, Rat
-
分类: 科研抗体货号: P00184别名: K-REV, RAL1B应用: WB,IHC反应种属: Human, Mouse, Rat
-
分类: 科研抗体货号: P00203别名: AMPH2; AMPHL; SH3P9应用: WB反应种属: Human
-
分类: 科研抗体货号: P00155别名: ANX3应用: WB,IHC反应种属: Human, Mouse, Rat
-
分类: 科研抗体货号: P00180别名: ARF2应用: IHC反应种属: Human, Mouse, Rat

鄂公网安备42018502007531号
鄂公网安备42018502007531号

